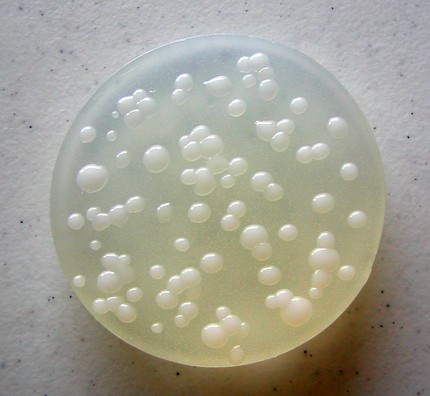
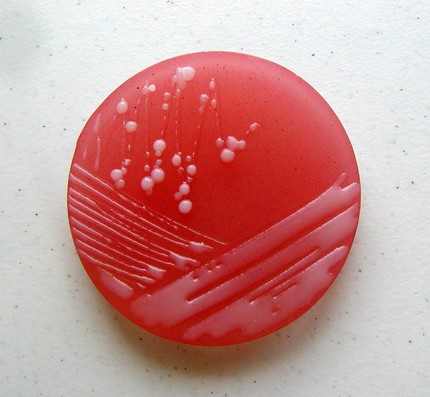

Latest

NO KINGS Day – Fort Collins – Oct 18, 2025

Open Letter to Ken Langone

Joel Koskan Send Off

Chess at the Dog Park

Not Getting Better
Time to Choose, GOP
What it’s NOT

Open Letter to Congress

FOP “Deeply Discouraged” – but Still With Trump

America the Braindead
Ballad of the Year

CU Admits Gender Discrimination

Perfect Light

End of Election

The Twelve Days of Christmas – Todd Lockwood
Wednesday, April 22, 2026